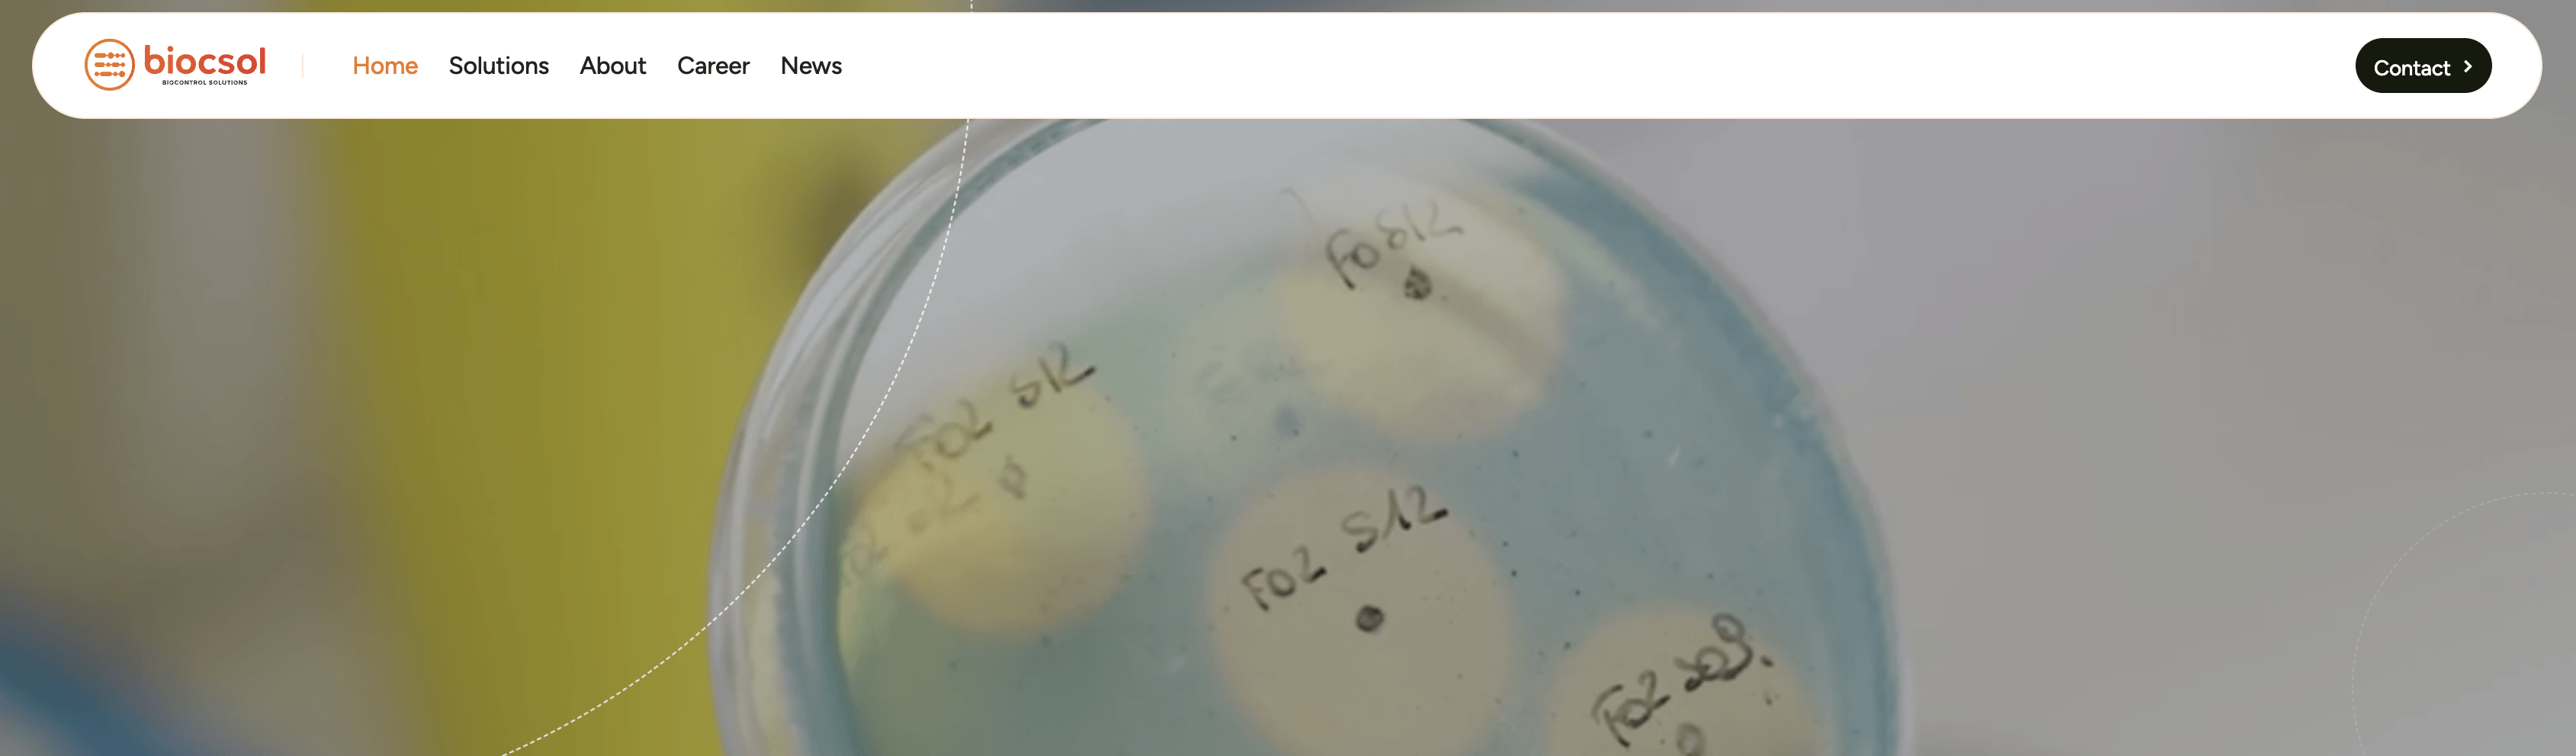

European agritech demonstrated measured resilience and strategic maturity amid a still-cautious investment climate. Rather than broad, hype-driven expansion, the sector showed clear signs of consolidation, technical depth, and stronger alignment with real on-farm and food-system needs.
More attention went to areas tied to efficiency and sustainability, using fewer inputs, improving animal and crop performance, and strengthening resilience to climate and cost pressures. Indoor and controlled-environment growing continued to develop, but with a stronger focus on energy use, automation, and making the economics work. Digital tools also shifted toward helping farmers make clearer decisions, rather than simply collecting more data.
The following are the ten largest funding rounds in the European agritech industry during the first half of 2025.

First Water (Iceland)
Amount raised in H1 2025: €39M
First Water is an Icelandic aquaculture company developing sustainable, land-based Atlantic salmon farming in Þorlákshöfn.
Using advanced closed-containment technology, clean subterranean seawater, and Iceland’s renewable energy, the company aims to produce high-quality salmon while reducing environmental impact. Its approach supports strong biosecurity, stable growing conditions, and responsible production as it scales its multi-phase facility for both domestic and international markets.
In April, First Water secured €39 millon to promote sustainable salmon production.

Fyteko (Belgium)
Amount raised in H1 2025: €13M
Fyteko is an agri-biosolutions company founded in 2014 that develops bio-based plant solutions for more sustainable agriculture.
Inspired by nature and backed by science, Fyteko builds proprietary, chemically pure biomolecules used in biostimulants and biocontrol to improve crop performance, strengthen drought/heat resilience, and reduce reliance on conventional chemicals.
In February, Fyteko landed €13 million to create biomolecules that protect and enhance the world’s crops.

Doktar (Türkiye)
Amount raised in H1 2025: €7.5M
Doktar is an agricultural technology company leading digital transformation in farming.
Founded in 2017, it combines proprietary software, IoT devices, hyper-local weather forecasts, satellite imagery, soil analysis, and AI-driven models to deliver data-driven insights from field to market. Doktar helps farmers, agribusinesses, and food companies optimise operations, reduce input costs, and support more sustainable and efficient agricultural production.
In June, Doktar raised €7.5 million to expand its product portfolio and scale its holistic service model globally.

Agteria Biotech (Sweden)
Amount raised in H1 2025: €6M
Agteria Biotech is an agricultural biotech startup on a mission to reduce global greenhouse gas emissions by tackling methane from cattle, a major climate contributor.
The company has developed AB-01, a patent-pending feed additive designed to significantly lower methane production in cows in a scalable, affordable, and science-backed way without disrupting normal digestion.
Agteria collaborates with leading researchers and partners to bring its solution to market and support more sustainable livestock farming.
Agteria Biotech raised €6 million in February to reduce methane emissions from cattle.

Avisomo (Norway)
Amount raised in H1 2025: €5M
Avisomo is an agricultural technology company specialising in automated vertical farming and plant factory solutions designed to integrate with large-scale retail and food supply chains.
Its modular systems enable cost-efficient, year-round cultivation of high-quality produce with minimal human interaction. Avisomo’s end-to-end solutions help reduce operational costs, improve scalability, and support sustainable indoor crop production.
In January, Avisomo secured €5 million in funding to advance its indoor farming technology and support sustainable, large-scale local food production.
BiocSol (Belgium)
Amount raised in H1 2025: €4.4M
Biocsol is an agricultural biotechnology company focused on developing biological solutions for sustainable crop production.
The company specialises in bio-based products that support plant health, improve resilience, and help protect crops while reducing reliance on conventional chemical inputs.
By combining scientific research with practical agricultural needs, Biocsol aims to contribute to more efficient, environmentally responsible farming systems.
In February, BiocSol raised €4.4 million to advance its R&D platform and to demonstrate global proof of concept for its first two biofungicide products.

Antler Bio (Ireland)
Amount raised in H1 2025: $4.3M
Antler Bio is an agri-biotech company transforming dairy farming with its EpiHerd platform, which combines gene expression analysis and artificial intelligence to generate actionable insights at the herd and individual animal level.
By linking genetics, environment, and farm management, the platform helps farmers improve milk yield, animal health, fertility, and longevity.
Antler Bio’s approach enables earlier, more precise decision-making, supporting more efficient, profitable, and sustainable dairy production across Europe and beyond.
In June, Antler Bio secured a $4.3 million investment to scale its world-first EpiHerd system.

Collie (Netherlands)
Amount raised in H1 2025: €3.5M
Collie is an agritech company that uses artificial intelligence to improve demand forecasting and supply chain efficiency for fresh produce.
Its AI-driven platform helps growers, distributors, and retailers better predict demand, reduce food waste, and optimise planning by turning complex data into accurate, actionable insights.
By increasing transparency and efficiency across the value chain, Collie supports more sustainable and profitable fresh food systems.
Collie secured €3.5 million investment in February for digital livestock management.

BlueRedGold (Sweden)
Amount raised in H1 2025: €2.73M
BlueRedGold is a company focused on producing premium saffron through controlled-environment agriculture and technology-driven cultivation methods.
By growing saffron indoors under optimised conditions, the company ensures consistent quality, purity, and year-round production while significantly reducing water use and environmental impact.
BlueRedGold combines agricultural innovation with full traceability and quality control, aiming to scale sustainable saffron production and make this high-value spice more accessible to global food, beverage, and wellness markets.
In June, BlueRedGold raised €2.73 million for an automated saffron cultivation system.

Fotenix (UK)
Amount raised in H1 2025: £2.1M
Fotenix is a climate technology company developing advanced photocatalytic solutions to capture and convert carbon dioxide into valuable products.
By combining proprietary materials science with scalable reactor systems, Fotenix enables carbon utilisation across industrial applications, helping reduce emissions while creating new economic value.
The company’s technology supports the transition toward a circular, low-carbon economy by turning waste CO₂ into a resource rather than a liability.
In April, Fotenix secured £2.1 million in new funding to help farmers detect disease and protect yields, weeks before symptoms appear.


Would you like to write the first comment?
Login to post comments